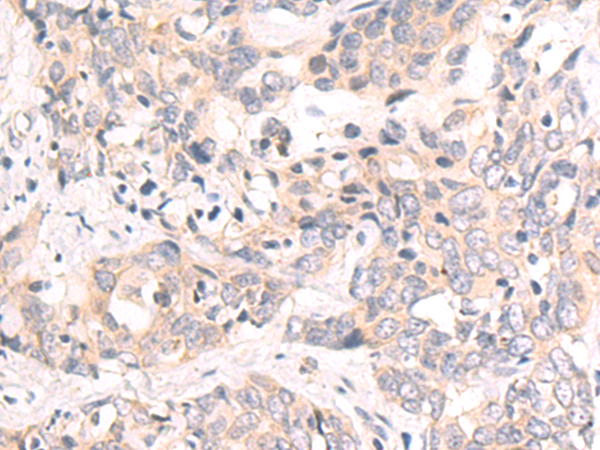

-
分类: 科研抗体货号: P05544别名: IRP; INT1L1应用: WB,IHC反应种属: Human, Mouse
-
分类: 科研抗体货号: P05595别名:应用: WB,IHC反应种属: Human, Mouse
-
分类: 科研抗体货号: P05648别名:应用: IHC反应种属: Human, Mouse
-
分类: 科研抗体货号: P05539别名: PRKWNK3应用: WB,IHC反应种属: Human, Mouse
-
分类: 科研抗体货号: P05588别名: AQPX1应用: IHC反应种属: Human
-
分类: 科研抗体货号: P05644别名: DEFB-12应用: IHC反应种属: Human
-
分类: 科研抗体货号: P05538别名: PHP; GHDX; MRGH; PHPX; SOXB应用: WB,IHC反应种属: Human, Mouse
-
分类: 科研抗体货号: P05578别名: K20; CD20; CK20; CK-20; KRT21应用: WB,IHC反应种属: Human, Mouse, Rat
-
分类: 科研抗体货号: P05638别名: ACPL; CD218b; IL-1R7; IL18RB; CDw218b; IL-1R-7; IL-18RAcP; IL-1RAcPL; IL-18Rbeta; IL-18R-beta应用: WB,IHC反应种属: Human, Mouse
-
分类: 科研抗体货号: P05574别名: CST; SRG; CAS11; ZNF693; dJ734G22.1应用: IHC反应种属: Human, Mouse

鄂公网安备42018502007531号
鄂公网安备42018502007531号

